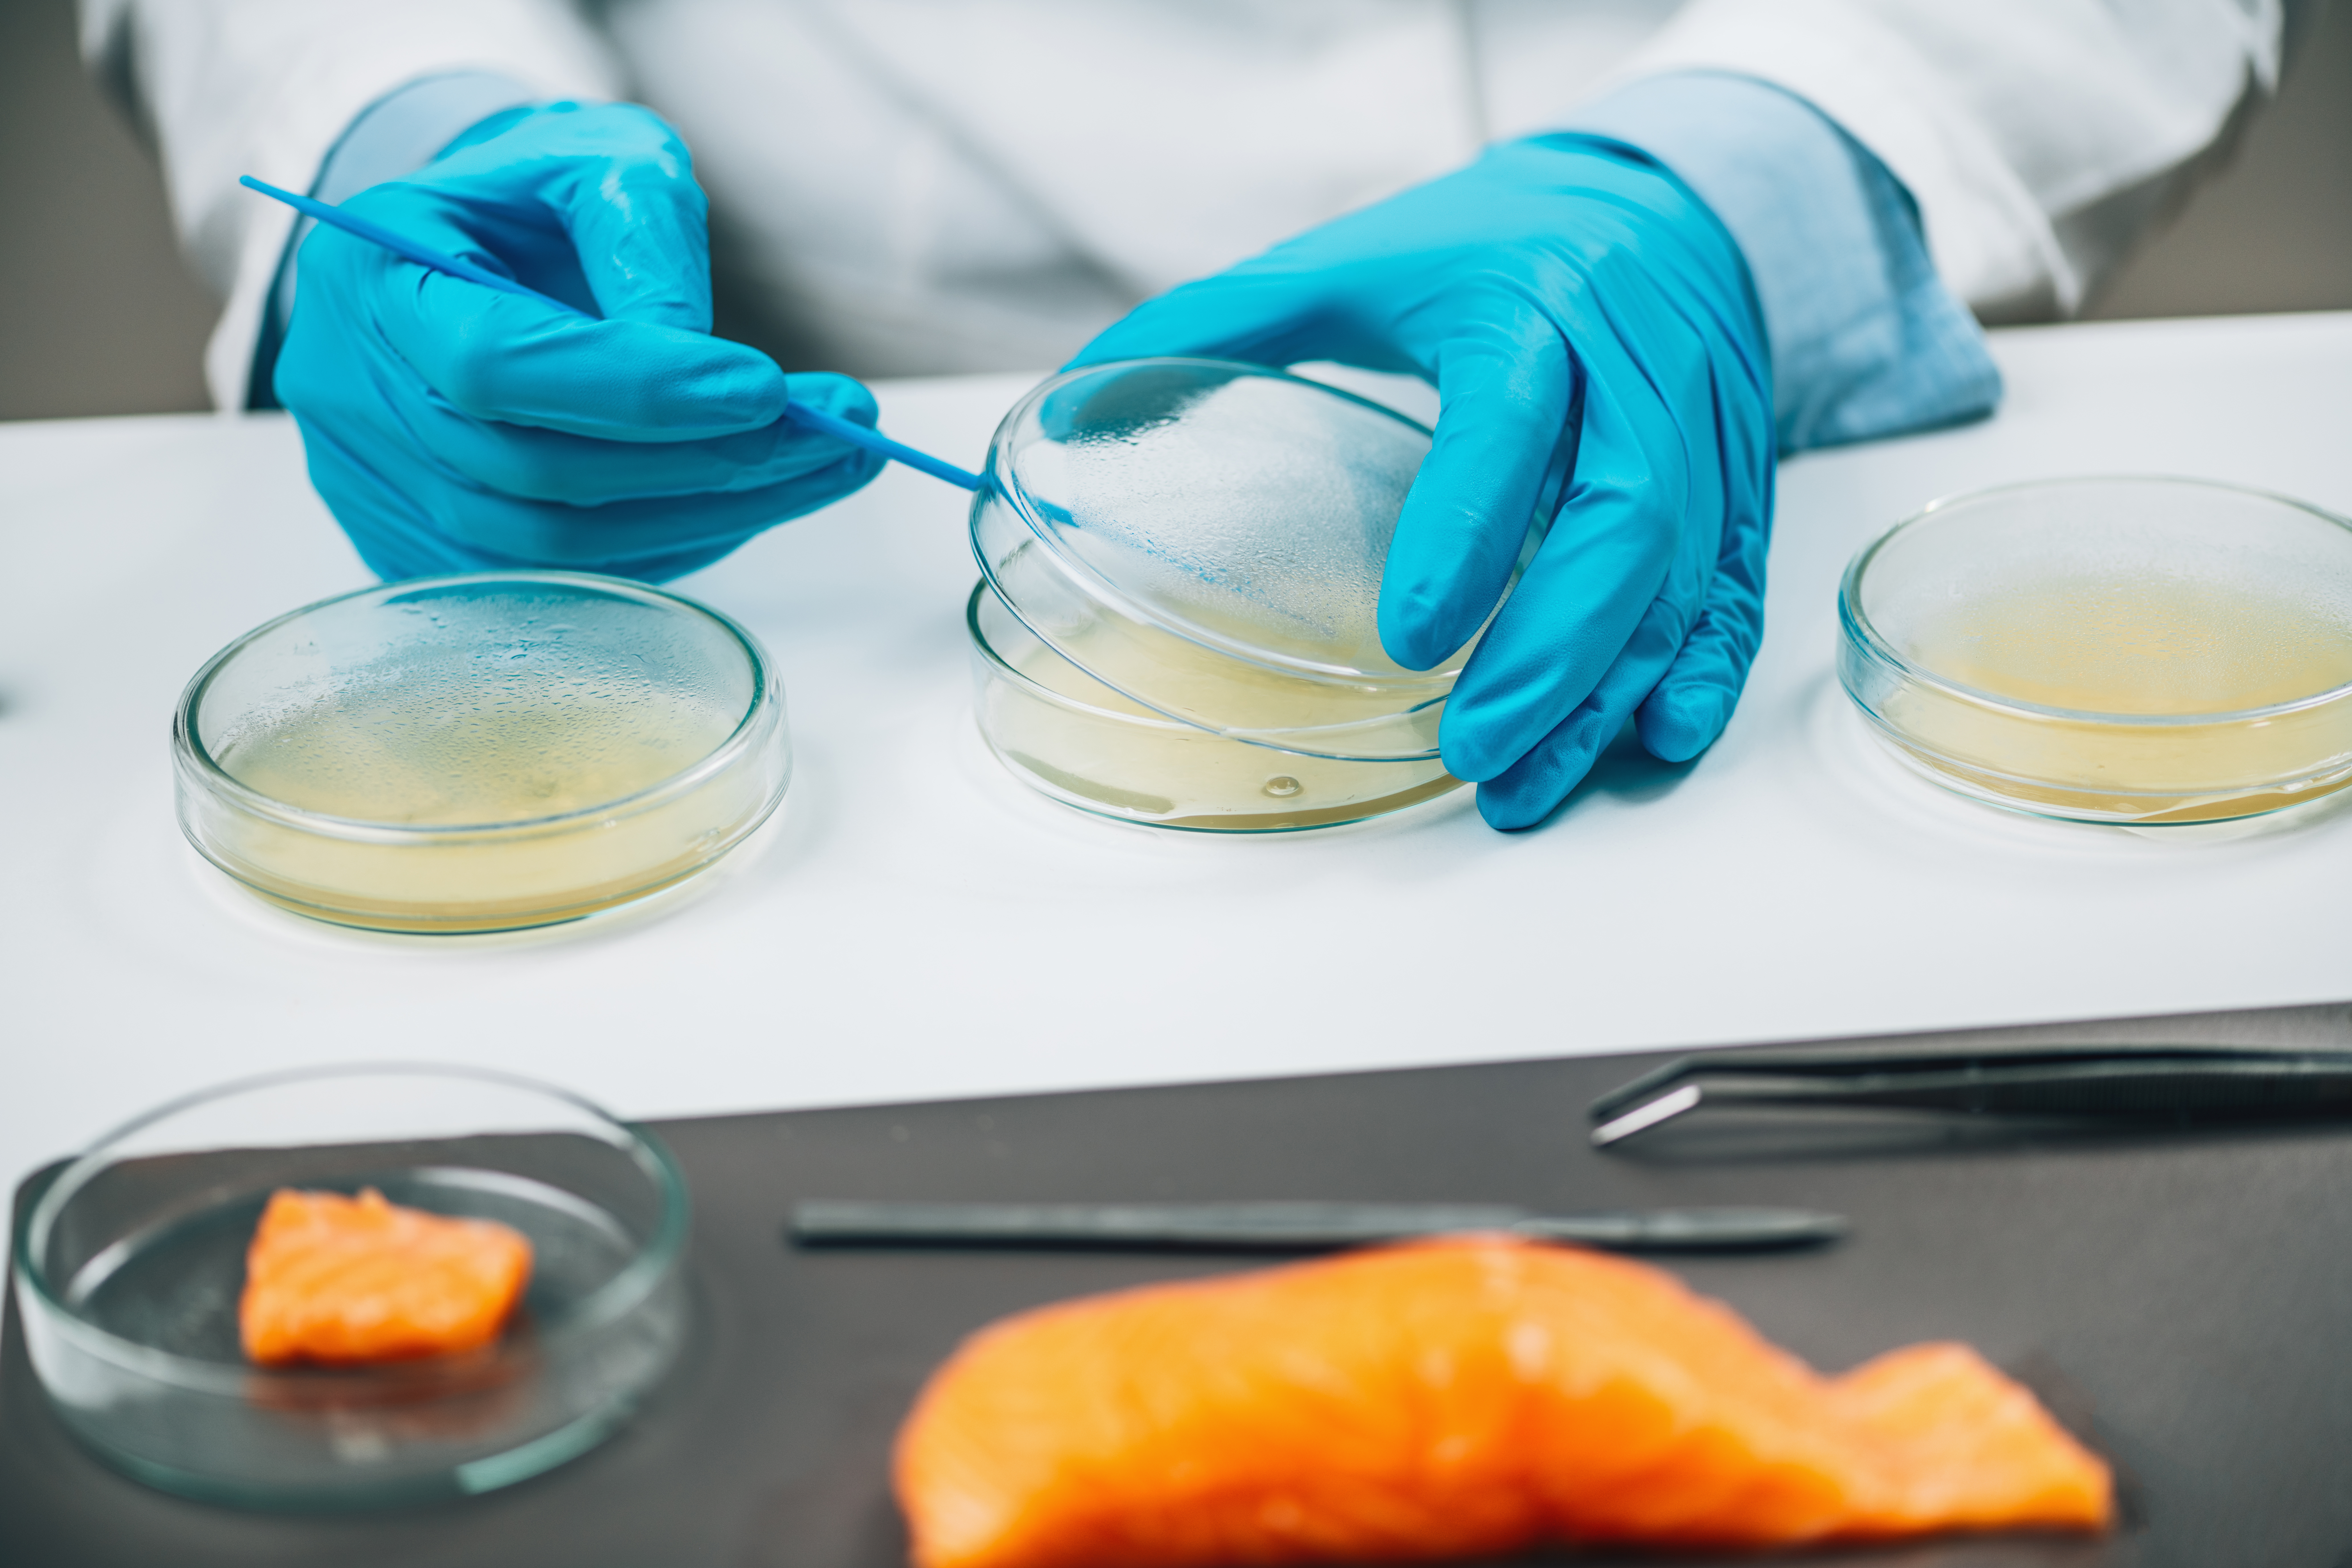

Salmon sperm or Salmon DNA (PDRN) is the new trend in anti-aging. It’s packed with anti-aging benefits making skin glow like “glass.”
Why is Salmon Sperm the newest rave?
Salmon DNA sperm has been getting a lot of press lately. The sperm is harvested from the salmon trout or chum salmon. It’s the rave in Korean anesthetic medicine used by the majority of dermatologists for facial and skin rejuvenation and is gaining popularity in the U.S. No worries, it’s not raw salmon sperm lathered on the face, but a highly purified (95%) DNA fragments called PDRN (Polydeoxyribonucleotide). PDRN goes to the cellular layer of skin (deeper layers) to stimulate collagen by turning on specific cellular pathways. When applied properly it makes skin look younger, and glow.
Salmon sperm DNA is unique in that it has a very similar structure to human DNA (backbone of the cell) so ideal for skin and facial rejuvenation. In the U.S, it can be used as a topical cream or serum applied alone or with another anesthetic procedure like microneedling, or facial resurfacing where the deeper layer of the skin (dermis) can be reached for the best cosmetic and anti-aging effect.
How does Salmon PDRN work for Anti-Aging?
Fighting against Aging is one of the great challenges of our century. Science Direct says the first signs of aging are those pesky fine lines, wrinkles, and sagging skin.
Salmon PDRN or DNA fragments can help block aging in the skin. It is made of highly purified DNA (that mimics human DNA) that works on the cellular level by “turning on,” special A2A (adenosine) receptors in the skin that is linked to many positive benefits. It increases collagen or the building blocks of the skin, speeds up tissue regeneration from environmental stress, and works on melanin or the pigment in skin to decrease the look of dark spots and when injected into the scalp can even grow hair.
Since it’s ultra purified Salmon sperm DNA all proteins and allergy causing particles are removed. It is very safe and unlike other serums or injectables rarely causes an allergic reaction. It works best for anti-Aging when injected as a filler or serum targeted at the deeper layers either after microneedling or skin resurfacing when there is exposure to the dermal layers. It can also be applied directly to the surface skin.
In the U.S. use of PDRN is not FDA approved as injectables or skin fillers but continues to gain popularity by dermatologists and health spas alike either as a serum or for microinjections as an “off label,” use. It appears to be a safe and effective with the most common side effects when injected are redness, and bruising. A study reported that 80 % or more of Korean dermatologists are using Salmon DNA fillers in their patients. Common brands include Rejuran and Nucleofill.
How does Salmon PDRN compare with traditional fillers?
A new article by Applied Science says PDRN technology has been around since the 1990s and used mostly in wound healing and burn victims to increase local blood flow to damaged tissues and decrease inflammation. In 2008 it was introduced into the dermatology and the cosmetic community and gained popularity in 2023 for anti-Aging and now can be seen on TikTok as the latest rave. It’s available as an injectable, cream and serum.
When PDRN is used as an injectable filler it’s most effective as penetrates to the deep dermal layers stimulating collagen improving skin texture, wrinkles, and glow. When applied as a serum to the skin it gives a glowing or “glassy,” sheen but without the Anti-aging properties seen at deeper layers.
Compared with traditional dermal fillers made from hyaluronic acid (HA), the HA acts more as a “volume,” booster but without the benefit of collagen stimulation, cellular regeneration, and anti-aging effects. HA fillers have more side effects including localized reaction, nodules, and even granulomas or areas of scarring. However, HA gives you that immediate “lift,” filling in hollow spaces and wrinkles unlike PDRN where rejuvenation takes time.
Is there a Vegan version of Salmon PDRN?
Yes, there is a vegan PDRN that instead of made by Salmon DNA is plant based made from Korean wild ginseng that seems to have similar anti-aging properties. Plant based PDRN has even fewer allergic reactions as animal DNA tends to be more immunogenic. Plant based DNA fragments are an alternative to Salmon sperm derived PDRN that can stimulate growth, decrease inflammation, and promote wound healing in skin.
Any last advice of Salmon sperm PDRN and Anti-Aging?
Salmon sperm PDRN or highly purified DNA is gaining in popularity for natural skin and face rejuvenation giving us that special “glow,” and “glassy,” finish and can also stop anti-aging at the cellular level beneath the skin. Despite its excellent safety profile worldwide especially in the Korean skin care industry it is still not FDA approved in the U.S. for injection use.
It is approved in the U.S. to be added to serums and creams and can be very effective at anti-Aging when combined with microneedling or skin resurfacing often called a “Salmon sperm facial,” where a device creates microchannels to allow PDRN serums to penetrate deeply into the dermis.
We need only check out Tik Tok or Hollywood Reporter saying this is the “Key to Eternal Youth,” as Celebrities like Jennifer Aniston and Denise Richards are adding to their skin care regimens.
If you are in need of a quick pick me up, consider at your microneedling or skin resurfacing to add on either plant-based PDRN or Salmon PDRN or just ask for the Salmon sperm facial. It’s safe and a natural way to turn back time or at least give you that glowy look to make you feel and look great.
If you have any questions AskDoctorH, we are here to help.

Have Questions? AskDoctorH
Have Questions? AskDoctorH